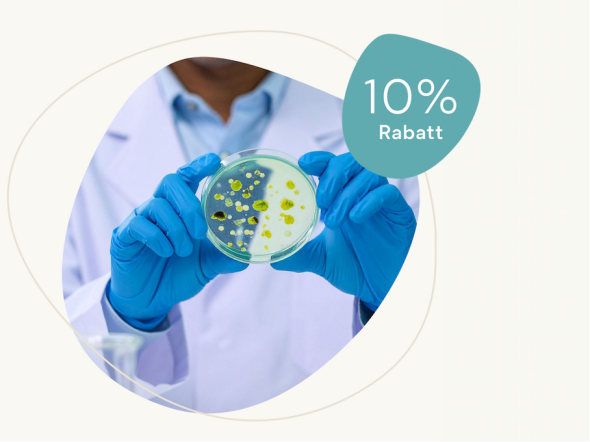

Was wirklich im Hundefutter steckt
Sehr geehrte Damen und Herren,
der Markt für Hundenahrung ist riesig und die Verpackungen versprechen viel:
„Natürlich“
„Premium“
„Mit frischem Fleisch“
Doch was bedeutet das konkret? Sind das Worthülsen oder steckt etwas dahinter?
Wir möchten heute transparent erklären, warum wir uns für einen anderen Weg entschieden haben.
Denn die herkömmliche Tierfutterindustrie arbeitet mit vielen Prozessen und Zusatzstoffen, die die wenigsten Hundehalter kennen – und die Sie vielleicht schockieren werden.
So sind beispielsweise bei der Verarbeitung hohe Temperaturen üblich.
Die Ausgangsstoffe werden auf bis zu180 Grad erhitzt, getrocknet und einer starken mechanischen Belastung ausgesetzt. Das führt dazu, dass die natürlichen Bestandteile stark verändert werden können und der Geschmack verloren geht.
Die hohen Temperaturen sind technisch effizient und industrietauglich, aber nicht immer ideal für empfindliche Rohstoffe.
Nach dem Trocknen werden viele Snacks überzogen, um den verlorenen Geschmack zu ersetzen, das sogenannte Coating. Es werden Aromastoffe, tierische Hydrolysate, Reaktionsaromen und Fette als Träger aufgesprüht.
Alle dieser Stoffe sind EU-rechtlich zugelassen und deklariert als sensorische Zusatzstoffe und Aromastoffe. Das verschleiert aber nicht, dass letzten Endes der eigentliche Geschmack oft erst durch die Beschichtung und nicht durch die Rohstoffe selbst entsteht.
Bleiben wir bei der EU-Verordnung. Nach dieser sind zahlreiche Nebenprodukte erlaubt und dürfen rechtmäßig verarbeitet werden.
Das klingt soweit harmlos, aber wenn wir uns vor Augen führen, was das unter anderem bedeutet, vergeht einem schnell der Appetit:
Köpfe, Füße, Knochen, Eingeweide, Blut und Haut vom Geflügel. Darunter auch geschredderte Küken.
Knorpel, Sehnen, Hufe und Plazenta vom Rind oder Schwein – großteils aus Massentierhaltung.
Und auch Fischreste, sprühgetrocknetes Plasma sowie Feder-, Fleisch- und Knochenmehl finden sich im Menü.
Sachlich formuliert könnte man also sagen, dass “gesetzlich zulässig” nicht automatisch bedeutet, dass es der Qualitätsanspruch jedes Hundehalters ist …
Damit diese Industriemischungen auch halten und einheitlich produziert werden können, greift man auf Füllstoffe und technologische Hilfsmittel zurück.
Cellulosefasern, Bindemittel und Verdickungsmittel sind Standard.
Ebenso wie Farbstoffe und Konservierungsstoffe, damit das Produkt “schön” aussieht und haltbar bleibt. Das mag technologisch sinnvoll sein, ist aber nicht zwingend ernährungsphysiologisch notwendig und entfernt sich deutlich von dem, was die Natur uns bietet.
Übrigens sind manche Stoffe wie etwa “Verarbeitungshilfsstoffe” nicht deklarationspflichtig.
Das heißt, sie tauchen überhaupt nicht auf dem Etikett auf, weil sie lediglich als Herstellungshilfe verwendet werden und nur noch in geringen Mengen im Endprodukt vorhanden sein sollen.
Dennoch können unsere Hunde sicher auch auf geringste Mengen von Filtrationshilfen (z. B. Kieselgur), Trennmittel in Maschinen, Lösungsmittel, Extraktionsmittel (z. B. Ethanol, CO₂), Enzymen und Klärhilfsmittel verzichten.
Und auch sehr gefährliche Stoffe wie Schwermetalle, Mykotoxin oder Dioxin können vorhanden sein – solange sie unter bestimmten Grenzwerten bleiben.
Zusammengefasst können wir sagen, dass der herkömmliche Tierfuttermarkt von starker Industrialisierung, hoher Standardisierung und Optimierung auf Kosten- und Prozesssicherheit dominiert wird.
Das System ist zweifellos effizient.
Aber mit Natur und Qualität hat das nicht mehr viel zu tun und ist nicht unser Anspruch bei Cellavita.
Daher ziehen wir eine klare Linie und verzichten auf Aromastoffe, Palatants und tierische Nebenprodukte. Bei uns gibt es keine unnötigen Zusatzstoffe und wir deklarieren transparent.
Schonende Verarbeitung in Zusammenarbeit mit Fachleuten ist Grundlage für das, wofür wir stehen.
Denn wir haben Ihr Tier im Blick und nicht industrielle Prozessoptimierung. Schließlich kann Ihr Hund nicht selbst entscheiden, was er zu Fressen bekommt.
Wir, die Menschen, geben es ihm.
Ihr 10% Rabattcode: tierliebe10
Wir wünschen Ihnen eine wundervolle Zeit mit Ihrem Hund und dass er ein langes und gesundes Leben hat.
Mit gesunden Grüßen
Ihr Cellavita-Team